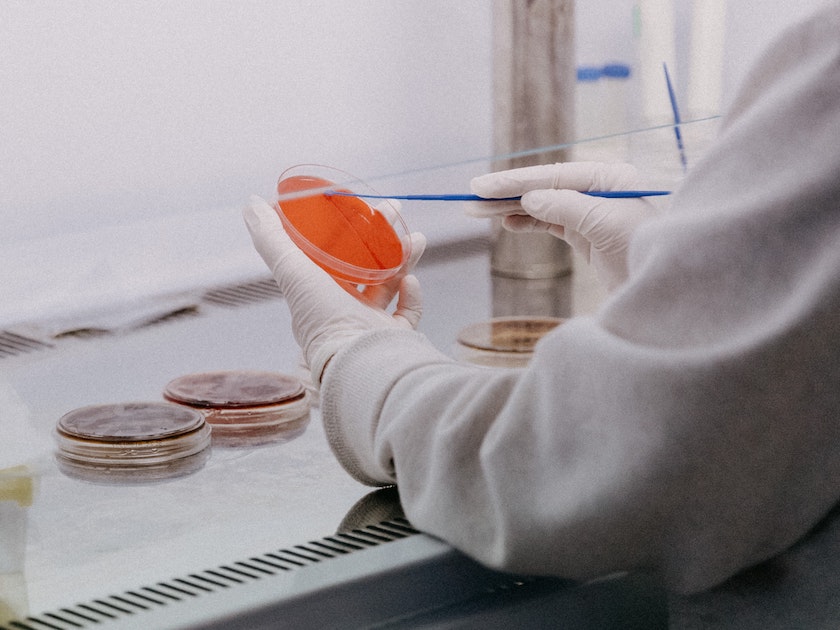

实习记者 郑正
2022年3月16日15时,上海举行疫情防控工作新闻发布会,介绍疫情最新情况。上海市市卫生健康委主任邬惊雷在会上通报,上海市新增1例新冠肺炎本土确诊病例和19例本土无症状感染者。
本次报告的1例确诊病例是由无症状感染者转归为确诊病例的。19例无症状感染者中,7例在集中隔离管控中发现,1例为外省返沪人员协查中发现,其余为相关风险人群筛查发现,均已闭环转运至上海市公共卫生临床中心隔离医学观察,目前情况稳定。
根据国务院联防联控机制有关要求和今天已经公布的确诊病例等相关情况,经上海市新冠肺炎疫情防控工作领导小组办公室研究决定,即日起将浦东新区惠南镇听悦路920号、闵行区江川路街道剑川路综合服务中心工地宿舍列为中风险地区,相关地区已落实管控措施。
同时,从2022年3月17日0时起,将松江区九里亭街道永辉超市沪亭北路店由中风险地区调整为低风险地区。上海市其他区域风险等级不变。
邬惊雷表示,对上海来讲,目前疫情防控进入非常关键阶段。而主动防控、精准防控、科学防控、综合防控,始终是上海在整个防控工作当中得以贯彻落实的,特别是在加强重点区域、重点人群、重点行业核酸检测力度有所加强。

“这些举措都是为了尽快实现社会面‘动态清零’,使市民群众基本恢复到日常生活,希望得到大家的理解、支持和配合。”邬惊雷说。

上海将用网格化方式对重点区域人群进行新一轮核酸筛查,如何展开?
上海市卫生健康委副主任赵丹丹介绍,这新一轮核酸筛查,其目的是尽早发现潜在传染源,切断传播途径,尽快实现社会面动态清零。
经过专家组研判,上海根据区域风险等情况,确定了一些重点区域。今明两天48小时内,将对这些重点区域内的人员进行2次核酸筛查。
对于既有已在闭环管理中的高风险岗位、已在例行排查工作机制的人员,按照原有机制继续开展例行筛查。重点区域核酸筛查,不采取“2+12”措施,各区要按照市里统一部署,不得擅自加码。
“为了确保本次核酸筛查安全、有序开展,全市很多工作人员都在连夜进行准备,组织了采样人员、公安民警、志愿者等队伍力量,配齐采样、检测试剂等物资。”赵丹丹向各位市民给予的理解和支持表示感谢,并做出了五点提醒。
一是筛查区域内的市民们应当在当时居住地保持原地相对静止,并在48小时内接受两次核酸检测。二是请大家按照所在街道(镇)工作人员的通知,到指定采样点开展核酸检测,确保不漏一户、不落一人。
三是检测前务必携带身份证、手机,提前在健康云进行登记,在采样现场请提前做好“登记二维码”的截图保存、展示和扫码准备。四是要听从现场工作人员的引导,采样过程中需规范佩戴口罩、间隔1米距离有序排队、遵守公共秩序。五是如筛查发现疑似阳性情况,按照现有疫情防控相关应急措施处置。
他表示,上海将进一步提升网格化核酸筛查工作的组织,有力有序地做好各项工作,为承担公共服务、城市运行、应急服务的保障人员开辟通道,为重点区域有就医等特殊需要的居民开辟绿色通道。而对有需要的市民,可开具在家落实防疫管理措施的相关证明,可以向居住地的居村委提出申请。

上海本轮疫情无症状感染者较多,为什么要对无症状感染者实施集中隔离医学观察?现在他们的情况怎么样?
据邬惊雷介绍,无症状感染者核酸检测是阳性的,但是临床和影像学上都没有什么表现。发现无症状感染者之后必须要按照国家防控方案报告,并采取相应的措施。
他表示,上海目前无症状感染者的比例与其他国家和地区数据趋同。从国际上看,前期新冠病毒感染者无症状呈逐步增多的态势,特别是近期奥密克戎为主要流行株后,无症状者可达80~90%。上海本轮疫情无症状感染者数量较多主要有三点原因。
一是本身奥密克戎毒株致病毒性降低。有研究资料显示,奥密克戎毒株感染主要累及上呼吸道,下呼吸道比较少,显著降低了有症状的比例。二是大规模人群的疫苗接种,为保护广大易感人群起到了非常重要的作用。
“根据我们对病例的研究分析,发现在所有病例中疫苗接种的比例达到94%左右,重症发生率降低至0.1%,更无一例发展至危重症。”邬惊雷指出,这些数据说明疫苗对于减轻症状有着非常重要的影响。
还有一个原因在于,主动筛查提高检测率后筛查出更多的无症状感染者,随着流行病学调查大量提前,筛查能力和范围更大,出现疫情后,相关密接者、次密接者、风险人群很快就被管控起来。邬惊雷表示:“这些措施使得处在潜伏期的感染者很快被发现,早期主动筛查中的无症状病例的比例也会随之升高。”
邬惊雷也强调,无症状感染者并不代表传染性低,所以对无症状感染者必须实行集中隔离措施,控制传染源,阻断传播。“控制传染源、切断传播途径、保护易感人群是控制传染性疾病的关键。”
而对无症状感染者医学观察管理需要,部分无症状感染者会出现病情的变化,尤其是在老年人、未注射过疫苗、肥胖、有严重基础疾病者,可能出现从无症状到有症状,甚至发展为重症,在医学观察期间便于医护人员及时发现救治。
关于对无症状感染者的治疗情况,邬惊雷指出,这些人的治疗与轻症者相似,会对他们进行临床观察随访,进行风险评估;同时,对原发病进行治疗,根据实际情况辅以中医药治疗,调整机体功能。
随着上海重点区域核酸检测筛查工作的展开,一些市民反映了做核酸时健康云打不开,导致社区核酸采样进度比较慢的问题,怎么办?
对此,邬惊雷回应道,为了确保正常运行,系统在访问量达到一定数值时实施了限流措施。“这可能会让系统有一点不畅,但并不是系统故障,更没有瘫痪,只是限流保护措施。”
本轮疫情发生后,核酸采样量持续攀升。3月11日起,核酸日均登记量和采样量均超500万。在前期高位运行的基础上,今天上午,系统核酸检测登记数量433万,比昨天同期增加了一倍。
“从目前来看,整个健康云系统是正常的。出现这样的情况给市民带来了不便,我们特别表示歉意。虽然我们当时预想到这些情况,但是还是有所不畅,只能紧接着采取限流措施。”邬惊雷表示。
他介绍,春节至今,系统已开展多轮升级扩容。针对较大规模核酸检测时系统运行遇到的问题,系统会抓紧进行优化,一是持续升级扩容,加强运行情况监测,一旦出现问题,第一时间干预处置,做到确保系统安全运行。
同时,上海也会加强随申办和健康云联动协同,上海市大数据中心主动做好相关技术对接。另外,他也请各区加强筛查组织,做到错时错峰、有序组织、分批采样,避免大人群同时排队等候登记健康云。
“如出现系统访问人数较多等情况,登记码可截屏保存,同样有效。”邬惊雷提醒市民,这样可以更加有效提高现场核验效率。如果查询核酸结果报告,也可通过“随申办”APP、“随申办”支付宝和微信小程序查询。

目前筛查范围比较广,很多市民核酸检测需求比较大,检查报告的需求也比较大,上海市经信委在核酸方面提供了哪些技术上的支持?
据上海市经济信息化委副主任刘平介绍,目前,上海市筛查范围比较广,核酸检测试剂库存已经达到1300万人份,每天产量近400万人份,最大日产能达885万人份,核酸试剂充足,可以满足当前检测机构的试剂需求。
上海市经信委积极动员各方力量,开展了三方面的工作,以全力提升核酸检测能力,保障市民对核酸检测及检查报告的需求。
一是全力新建增量核酸检测能力。协调核酸检测设备生产商向上海市检测机构供应检测设备,协调检测能力达标的企业获批开展检测服务,协调现有移动核酸检测车辆发放临时行驶车号牌。
通过各方共同努力,截至目前,在原有基础上累计新增核酸检测能力每天20万管,按照10混1测算的话,相当于上海全市新增200万人份的检测能力。刘平透露:“明天预计还可新增12.5万管;后续将持续增加检测能力,累计实现新增45万管、即新增最高450万人份的检测目标。”
二是充分挖掘存量检测潜力。通过协调高校、科研院所、生物医药企业等相关单位来调配具有核酸检测资质的260多名员工,组成“产业联军”,上海市临床检验中心紧急培训核酸检测操作人员近300人,全市200多名具有核酸检测操作经验、符合资质条件的200多人,驰援检测一线,共同保障本市核酸检测机构24小时不间断运转,释放检测潜能。刘平特别向他们无私无畏的责任担当表示了衷心的感谢。
三是加强采样和检测的调度匹配。按照上海全市统一部署,全力做好采样、运输、检测、报告等各环节衔接调度,加快从采样到出报告的速度。
“在这里,要再次感谢各机构、企业以及检测工作人员的辛勤付出。”刘平表示,“我们相信,在科学有序的组织调度下,在各方的协同配合下,全市能提供足够的核酸检测能力,满足检测需求,为疫情防控做好坚实保障。”

浦东新区作为全上海人口最多的一个区,当前形势下怎么做好疫情防控以及相关筛查工作?
浦东新区副区长晏波回应,浦东新区是上海的特大型城区,区域面积约占全市的1/5,常住人口总量约占全市的1/4,辖区有12个街道和24个镇;同时,浦东又是浦东国际机场、全国重要口岸和物流枢纽所在地,整体疫情防控形势复杂、任务艰巨。
在当前形势下,浦东新区正在按照上海市委、市政府部署要求,坚持“外防输入、内防反弹”总策略和“动态清零”总方针,结合浦东实际情况,举全区之力,坚决落实各项疫情防控举措。
晏波介绍,浦东采取了四项主要举措,以做好疫情防控以及相关筛查工作。
浦东新区针对本轮疫情隐匿传播、快速蔓延、早期发现更难的特点,在上海市疾控中心指导下,浦东综合运用“线索追踪法”和“扩大筛查法”,加大对首发例、集聚性病例追踪力度,同时抽调人员充实力量,迅速增加了50%流调支撑人员,大家夜以继日、不眠不休,努力与病毒赛跑。
同时,浦东正在按照上海全市统一部署,有力有序地扩大社会面筛查,开展重点区域扩大范围的筛查。
晏波表示,截至3月15日24时,浦东已在16个街镇组织了扩大筛查,累计覆盖119.6万人口。同时,该区也基本完成医疗卫生、交通运输、教育、商贸等重点行业的筛查。今天,浦东进一步在5个街镇开始了切块式、网格化的筛查。
对于近期市民普遍反映的核酸检测慢的问题,晏波回应,浦东正在围绕“采、转、检、报”四个环节,全力组织协调、努力挖潜增能,做到组织采样有序、运送环节畅通、报告及时上云、应急处置及时,提升核酸检测能力为更大范围的扩大筛查做好支撑保障。
针对浦东封控区域分布广、居民诉求多样的情况,为第一时间响应解决居民各类生活需求,浦东专门成立了民需回应专项工作组,直达一线,全力加强生活服务保障。
晏波透露,工作组的成立一方面保障生活物资,协调重点电商平台提升1.5-2倍备货量,优先调拨蔬菜、猪肉、米面粮油等刚需货源,保障物流畅通,确保居民生活必需品供得上、不断档;另一方面,建立就医绿色通道,积极调动医疗资源,全力保障封控区域居民就医需求。
他表示,接下来,浦东将按照全市部署要求,以坚定意志和坚决行动、以特殊担当和紧密协同,从严从紧、从细从实抓好疫情防控工作,坚决打赢疫情防控阻击战。




评论